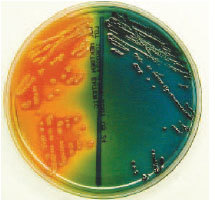
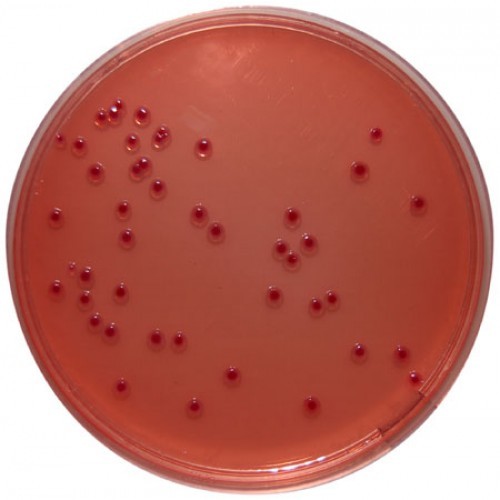

MacConkey
Key characteristics
Lactose fermenting organism will have pink colonies
Non-lactose fermenters will have colorless colonies
Inhibit: gram positive (crystal violet, bile salts)
Isolation and Differentiation: lactose fermenting and non-lactose fermenting enteric bacilli
Hectoen enteric agar- peptone base with bile salts, lactose, sucrose, salicin, and ferric ammonium citrate
Key Characteristics:
Enterics that ferment one or more of the carbohydrates will produce yellow to salmon colored colonies
Non-fermenters will produce blue-green colonies
H2S organisms will produce black or blue-green colonies
Indicators: bromthymol blue and acid fuchsin
Differential and Selective: Salmonella and Shigella from other gram negative enteric baccili

Xylose lysine desoxycholate (XLD) agar- Yeast extracts with lysine, xylose, lactose, sucrose, and ferric ammonium citrate
Key Characteristics
Enterics that ferment lactose/sucrose produce yellow colonies
Salmonella produces red colonies, some with black centers (H2S positive)
Shigella produces colorless colonies
Inhibits: gram positive (sodium desoxycholate)c
Isolation and Differentiation: Salmonella and Shigella from other gram-negative enteric bacilli
MacConkey Sorbitol
MacConkey Sorbitol- MacConkey agar but with sorbitol instead of lacose
Selective and Differentiation: E.coli 0157:H7 in stool
Organisms:
Escherichia coli: only 0157:H7 will grow

Thiosulfate citrate-bile salts agar (TCBS)- peptone base with bile salts, yeast extract, citrate, sucrose, ferric acid, and thiosulfate.
Key Characteristics:
Non-Vibro H2S Organism produce small black colonies
Sucrose fermenting Vibros produce blue colonies
Other Vibros produce various colors of yellow, green, and blue
Selective and Differential: Vibro spp.
Tetrathionate broth
Tetrathionate broth- peptone base broth with enzyme tertethionate
Key Characteristics
Tetrathionate positive organisms will grow (Salmonella, Shigella, Proteus)
Tetrathionate negative organisms are inhibited (E. coli)
Inhibit: gram positive and Enterobacteria (iodine, potassium iodide, bile salts, sodium thiosulfate)
Selective: Salmonella and Shigella (except S. typi)
Cefsulodin-irgasan-novobiocin agar (CIN)- Peptone base with yeast extract, mannitol, and bile salts, supplemented with cefsulodin, irgasan, and novobiocin.
Key Characteristics:
No Growth of non-Yersinia organisms
Yesrsinia organism appear colorless-pink-red (may have zone of precipitate bile)
Selective: Yersinia spp (may be useful for isolation of Aeromonas)
Organisms:
Yersinia enterocolitica: dark red culls-eye colonies
SS agar is selective for
Salmonella and Shigella
Centrimide agar is selective for
Pseudomonas aeruginosa
BCYE agar grows
Legionella pneumophilia
Selenite agar is selctive for
Salmonella and Shigella
PC and OFPBL agars grow
Burkholderia cepacia